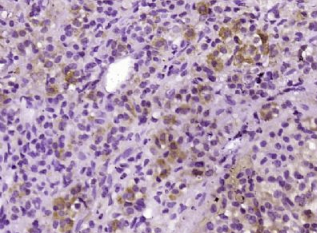

英文名称:Anti-ACTH (1-39)
中文名称:促肾上腺皮质激素(1-39)抗体(ACTH 1-39)
抗体来源:兔子
克隆类型:多克隆
交叉反应:人、小鼠、大鼠、牛、山羊
产品应用:ELISA=1:500-1000 IHC-P=1:400-800 IHC-F=1:400-800 IF=1:100-500(石蜡切片需做抗原修复)
尚未在其他应用程序中测试。
用户终应确定合适稀释浓度。
分子量:4.5kDa
细胞定位:分泌型蛋白
状态:冻干或液体
浓度:1mg/ml
来源于:KLH conjugated synthetic peptide derived from human ACTH:1-39/39
亚型:IgG
纯化方法:affinity purified by Protein A
储存液:0.01M TBS(pH7.4) with 1% BSA, 0.03% Proclin300 and 50% Glycerol.
别 名:Adrenocorticotropic hormone; Adrenocorticotropin; Adrenocorticotropin Hormone; Alpha Melanocyte Stimulating Hormone; Beta Lipotropin; Beta Melanocyte Stimulating Hormone; CLIP; Corticotropin; Corticotropin Like Intermediary Peptide; Corticotropin lipotropin precursor; Lipotropin Beta; Lipotropin Gamma; LPH; Melanotropin Alpha; Met Enkephalin; MSH; NPP; POC; POMC; Pro opiomelanocortin; Proopiomelanocortin; COLI_HUMAN.
保存条件:在-20°C下保存一年。避免重复冻融循环。冻干抗体在室温下至少稳定一个月,并在-20°C下保持一年以上。当在无菌pH7.4 0.01M PBS或抗体稀释剂中重组时,抗体在2-4°C下至少稳定两周。
产品介绍
该基因编码一种多肽激素前体,通过被称为前激素转化酶的枯草杆菌蛋白酶样酶分解进行广泛的组织特异性翻译后加工。多肽前体内有8个潜在的裂解位点,根据组织类型和可用的转化酶,加工可产生多达10个涉及多种细胞功能的生物活性肽。编码蛋白主要在垂体前叶的促肾上腺皮质细胞中合成,该细胞有四个分裂位点;促肾上腺皮质激素是正常类固醇生成和维持正常肾上腺重量所必需的,促脂蛋白β是主要的终产物。在其他组织中,包括下丘脑、胎盘和上皮,所有的卵裂部位都可以被使用,从而产生在疼痛和能量平衡、黑素细胞刺激和免疫调节中起作用的肽。这些包括几种不同的促黑素、促脂素和内啡肽,它们包含在促肾上腺皮质激素和β促脂素肽中。该基因突变与早发性肥胖、肾上腺功能不全和红发色素沉着有关。另外,还描述了编码相同蛋白质的剪接转录变体。[由RefSeq提供,2008年7月]。
功能:
促肾上腺皮质激素刺激肾上腺释放皮质醇。
MSH(黑素细胞刺激激素)通过增加黑素细胞中黑素的产生来增加皮肤的色素沉着。
β-内啡肽和甲脑啡肽是内源性阿片类药物。
亚细胞位置:
分泌的
组织特异性:
促肾上腺皮质激素和促肾上腺皮质激素由垂体产生。
翻译后修改:
在成对的碱性残基处的特异性酶切产生不同的活性肽。
O-糖基化;还原糖可能是N-乙酰半乳糖胺。
疾病:
POMC缺陷可能与肥胖(肥胖)易感性有关[MIM:601665]。它是一种以体重增加超过骨骼和身体需求限制为特征的疾病,是由于身体脂肪过度积聚的结果。
pomc缺陷是引起阿片黑素原缺乏(pomcd)的原因[mim:609734]。受影响的个体出现早发性肥胖、肾上腺功能不全和红发。
相似性:
属于庞克家族。
重要注意事项:
促肾上腺皮质激素(Adrenorticotrophin hormons, ACTH)是垂体前叶细胞分泌的一种多肽激素,是肾上腺皮质活性的主要调节者。
此抗体可与人的ACTH反应,与多种其它哺乳动物的ACTH有交叉反应,可用于垂体腺瘤的功能性分类,有助于区分原发性和转移型垂体肿瘤,嗜络细胞瘤等部分神经内分泌肿瘤也可出现阳性反应.
本产品仅用于研究用途,不用于人类、治疗或诊断应用。
多聚甲醛固定,石蜡包埋(人垂体瘤);用柠檬酸钠缓冲液(pH6.0)煮沸15min后获得抗原;用3%过氧化氢阻断内源过氧化物酶20分钟;阻断缓冲液(正常山羊血清)37℃30min;抗体(ACTH(1-39))多克隆抗体,未结合AT 1:400在4°C下过夜,然后用结合二级抗体进行20分钟的DAB染色。
公司优势:
1)质量:我司提供的的试剂为世界。
2)价格:价格实惠,量大从优。
4)服务:提供完整的售前、售后和售中服务。售后到底。
如需订购促肾上腺皮质激素(1-39)抗体(ACTH 1-39),请联系我们。
| Anti-OXR (Orexin receptor) 食欲素受体抗体 |
| Anti-P14ARF 抑癌基因p14抗体 |
| Anti-P16/CDKN2A (Cyclin-dependent kinase inhibitor-2A) 抑癌基因p16抗体 |
| Anti-P19ARF p19ARF抑癌基因抗体 |
| Anti-P21/WAF1/CIP1 p21抗体 |
| Anti-P27/kip1 (cyclin-dependent kinase inhibitor 1B) P27抗体/周期素依赖激酶抑制剂 |
| Anti-P2Y1 receptor P2Y1受体抗体 |
| Anti-P311 protein 神经再生相关蛋白抗体 |